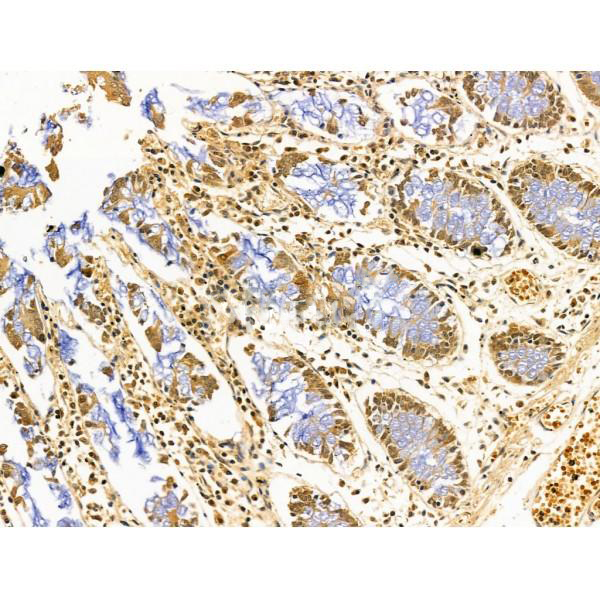

Sequence-specific DNA-binding protein that interacts with inducible viral and cellular enhancer elements to regulate transcription of selected genes. AP-2 factors bind to the consensus sequence 5'-GCCNNNGGC-3' and activate genes involved in a large spectrum of important biological functions including proper eye, face, body wall, limb and neural tube development. They also suppress a number of genes including MCAM/MUC18, C/EBP alpha and MYC. AP-2-alpha is the only AP-2 protein required for early morphogenesis of the lens vesicle. Together with the CITED2 coactivator, stimulates the PITX2 P1 promoter transcription activation. Associates with chromatin to the PITX2 P1 promoter region.
Description
Rabbit polyclonal antibody to AP2 alpha
Applications
WB, IF, ICC, IHC.
Immunogen
AP2 alpha Antibody detects endogenous levels of total AP2 alpha.
Reactivity
Human, Mouse, Rat.
可预测:Pig(100%), Zebrafish(%), Bovine(%), Horse(%), Sheep(%), Rabbit(%), Dog(%), Chicken(%), Xenopus(%)
Molecular weight
48 kDa; 48kD(Calculated).
Host species
Rabbit
Ig class
Immunogen-specific rabbit IgG
Purification
Antigen affinity purification
Full name
AP2 alpha
Synonyms
Activating enhancer binding protein 2 alpha; Activating enhancer-binding protein 2-alpha; Activator protein 2; AP 2 transcription factor; AP 2alpha; AP-2; AP-2 transcription factor; AP2; AP2 Transcription Factor; AP2-alpha; AP2A_HUMAN; AP2TF; BOFS; FLJ51761; TFAP 2; TFAP 2A; TFAP2; TFAP2A; Transcription factor AP 2 alpha (activating enhancer binding protein 2 alpha); Transcription factor AP-2-alpha; Transcription factor AP2 alpha;
Storage
Rabbit IgG in phosphate buffered saline , pH 7.4, 150mM NaCl, 0.02% sodium azide and 50% glycerol. Store at -20 °C. Stable for 12 months from date of receipt.
Swissprot
P05549




 产品订购:
产品订购:
 渠道电话:
渠道电话: